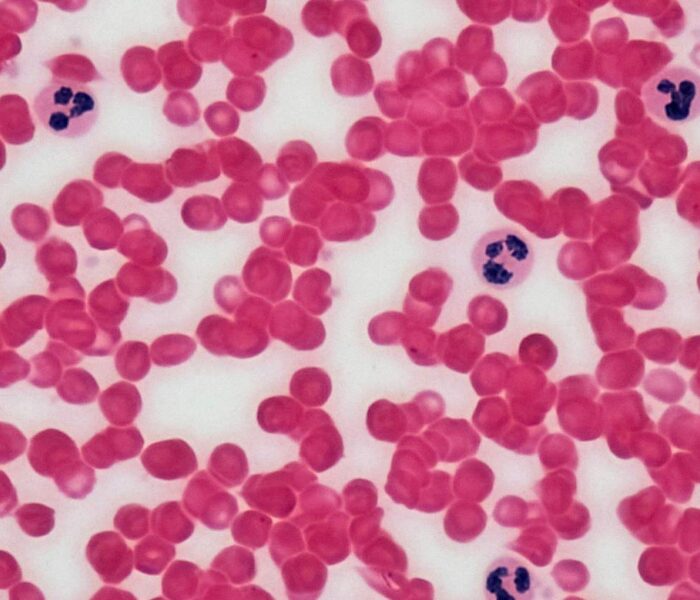

Multispecialty Care Under One Roof
Access advanced medical care across services including Cardiology, Neurology, Gastroenterology, Nephrology, and more — all guided by experienced specialist and modern diagnostic tools.
Technology-Driven Diagnostics
Equipped with 2D Echo, ECG, Multipara Monitoring, Infusion Pumps, and Home Sample Collection — Swasthya Hospital ensures accurate diagnosis and seamless treatment in every visit.
Patient-Centered Services
From executive health check-ups to chronic disease management and preoperative evaluations, we prioritize your long-term wellness with personalized care plans and easy appointment access.
About Swasthya Hospital
Your Journey to Better Health Starts Here
Swasthya Hospital is a 5-bed (24×7) center combining advanced diagnostics, AI-powered systems, and specialist-led care. Founded by Dr. Devansh Khandol, we deliver efficient, ethical, and personalized healthcare tailored to your comfort and convenience.
- Expert Doctor
- Trained staff
- Technologically advanced clinic management system
- Online appointment
- Multiple specialisation
- ABHA integration
- Teleconsultation
- Home sample collection

Our Services
Best Medical Services

State-of-the-Art Facilities at Swasthya Hospital
Experience cutting-edge technology and compassionate care with our advanced diagnostics and modern (24×7) facilities at Swasthya Hospital.
Cutting-Edge 2D Echocardiography — First in Kutch
Equipped with Kutch’s first advanced 2D Echo machine, we deliver precise cardiac imaging for early and accurate diagnosis, ensuring top-quality heart care right here in your community.
Modern (24x7) Facility for Efficient Treatment
Our 5-bed (24x7) setup provides high-quality, short-stay treatments with a focus on patient comfort, personalized care, and quick recovery — combining efficiency with compassionate medical attention.